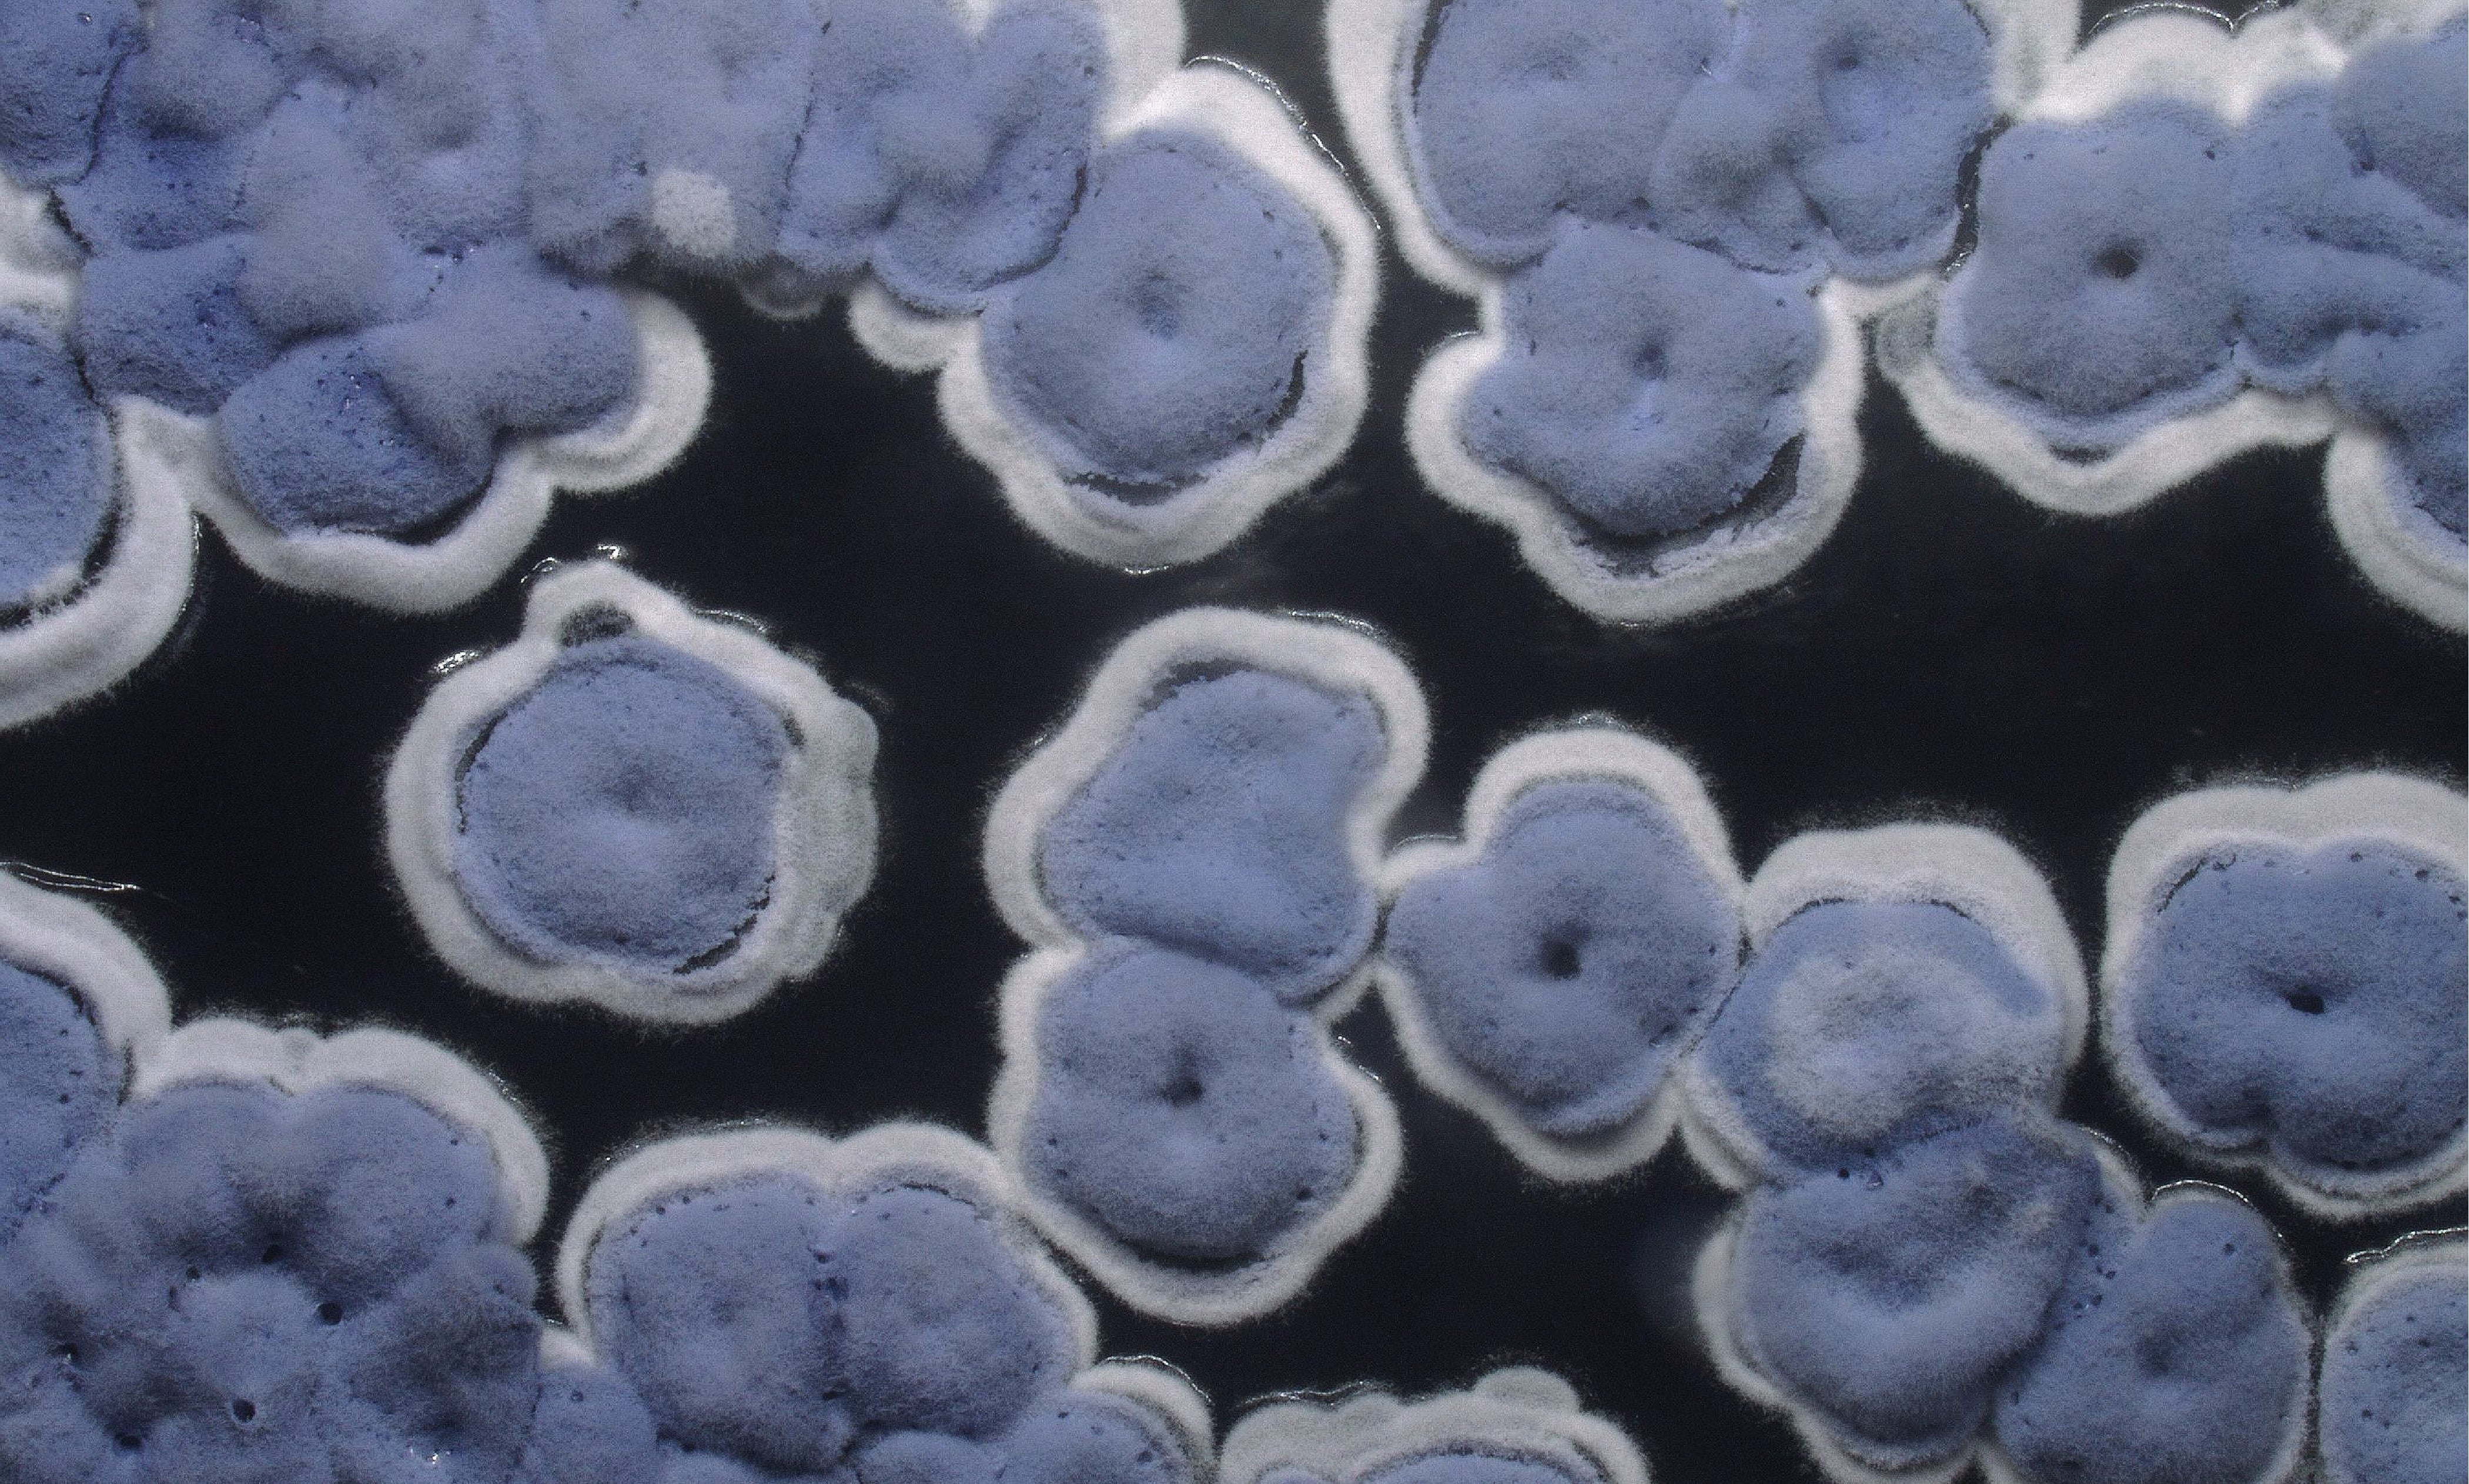
What if your next pair of jeans were grown, not sewn?
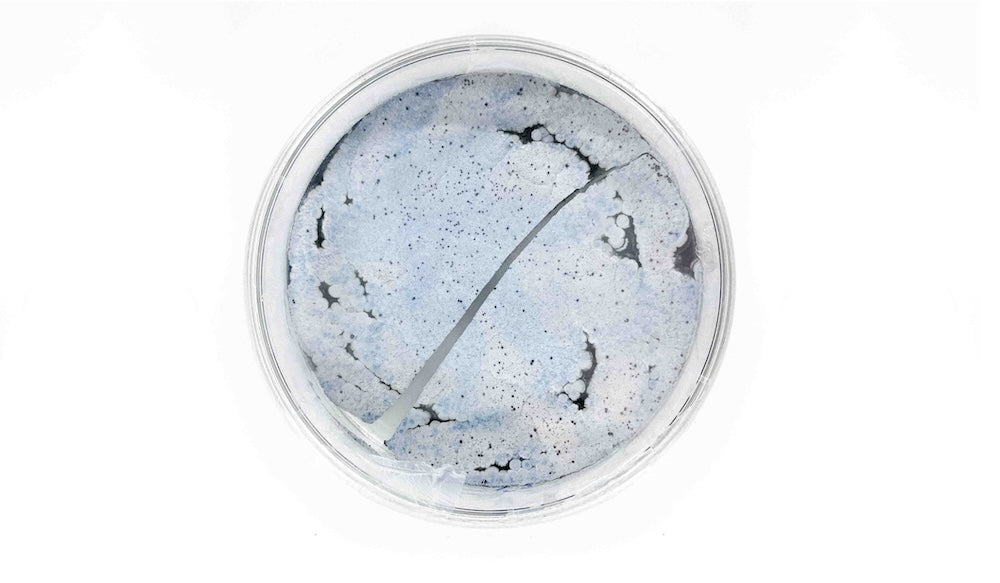
Image

What if your next pair of jeans were grown, not sewn?
Share article
Lab to Loom
Jeans are among the most widely worn garments on the planet. Their appeal lies in the details: a specific cut, a shaped pocket, a line of contrast stitching. These small choices carry traces of history, craftsmanship, and innovation. The basic design hasn't changed much in over 150 years. What has changed is the scale and speed of production and the environmental cost that comes with it.
Approximately 3.5 billion pairs of jeans are manufactured each year. Behind each pair is a trail of soil depletion, water contamination, poor labour conditions, and textile waste. The conventional denim industry is one of fashion's most resource-intensive sectors.
Lab to Loom asks a straightforward question: What if we could grow denim instead?
Developed by biodesigner Lotte, the project explores whether bacteria, not cotton plants, could become the foundation for textile production. It's an approach that uses agricultural waste as feedstock, requires minimal water, and eliminates dependence on pesticides and synthetic chemicals.


The process starts in the lab. Bacteria are cultivated under controlled conditions to produce two essential components: strong cellulose filaments and a rich blue pigment. These are processed together into indigo-coloured yarn. That yarn is then spun and woven using adapted traditional techniques. The result is fabric that's entirely bacterial in origin.

There's a conceptual parallel here with marine microbiology. In coastal ecosystems, bacteria naturally break down and rebuild organic matter. They're not passive agents; they respond to their environment and transform materials through biological processes. This project harnesses that same capacity, redirecting it toward textile production.
The benefits are tangible. The cultivation process uses agricultural waste streams, requires substantially less water than cotton growing, and needs no chlorine bleach or synthetic dyes. Even the minimal processing waste gets repurposed, transformed into the buttons on the garment's front fly.
Lotte, whose practice spans both bacterial biofabrication and traditional garment-making, constructs the jeans using zero-waste pattern cutting. The design integrates considerations for repair and adjustment, extending the garment's usable life. It's not just about growing a new material; it's about designing the entire system differently.




By presenting this innovation as something immediately recognisable, a pair of jeans, the project makes bacterial textiles tangible. You can see it, compare it to conventional denim, and understand what it might mean beyond the laboratory. This isn't proposing an overnight replacement for the existing industry. It's documenting a working methodology that proves technical viability.
Working with microbial systems, whether for skincare or textiles, reveals something fundamental: biotechnology isn't just a manufacturing tool. It's a design practice that requires different thinking. You work in cycles, not linear processes. Waste becomes feedstock. Biological timescales resist industrial acceleration. The microorganisms set parameters; human design adapts to microbial logic.
Both the skincare and fashion industries operate within consumption patterns built on novelty, volume, and rapid turnover. Microbial production resists that logic. It grows at its own pace, requires specific conditions, and produces materials that carry evidence of their biological origin. It suggests a different relationship to the objects we use; one that acknowledges the living systems involved in their creation.
Lab to Loom is a material investigation with practical implications for how we manufacture fabric and a demonstration of how microorganisms are quietly rewriting what's possible for industrial materials across multiple sectors.
References: Lotte Plumb


